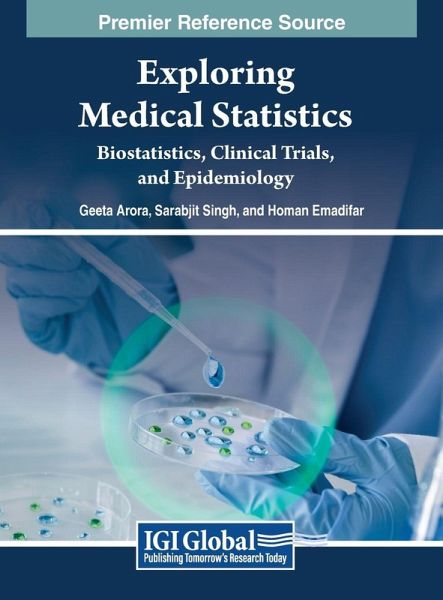

Exploring Medical Statistics
Biostatistics, Clinical Trials, and Epidemiology
Herausgeber: Arora, Geeta; Emadifar, Homan; Singh, Sarabjit
Versandkostenfrei!
Versandfertig in 1-2 Wochen
373,99 €
inkl. MwSt.
PAYBACK Punkte
187 °P sammeln!
In today's data-driven world, understanding and interpreting statistical information is more critical than ever, especially in medicine, where statistical methods are used to design and analyze clinical trials, study the distribution of disease in populations, and develop new treatments. In the era of evidence-based medicine, Exploring Medical Statistics: Biostatistics, Clinical Trials, and Epidemiology addresses the critical need for a grasp of statistical concepts. This book delves into biostatistics, clinical trials, and epidemiology, offering a robust foundation for understanding and inter...
In today's data-driven world, understanding and interpreting statistical information is more critical than ever, especially in medicine, where statistical methods are used to design and analyze clinical trials, study the distribution of disease in populations, and develop new treatments. In the era of evidence-based medicine, Exploring Medical Statistics: Biostatistics, Clinical Trials, and Epidemiology addresses the critical need for a grasp of statistical concepts. This book delves into biostatistics, clinical trials, and epidemiology, offering a robust foundation for understanding and interpreting statistical information in medicine. It explores biostatistics, elucidating fundamental elements such as probability, sampling, and hypothesis testing. The section on clinical trials covers the entire spectrum from trial design to ethical considerations, providing an invaluable resource for researchers navigating the complexities of medical research. Epidemiology, a cornerstone of public health, is examined in the book, offering insights into the distribution and determinants of diseases in populations. The application-focused section further extends the utility of medical statistics, encompassing public health, healthcare policy, and drug development.